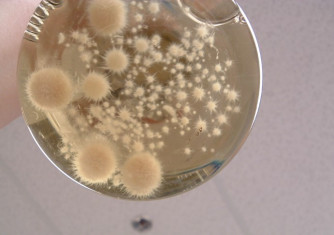

Nouveaux articles scientifiques au 490 (ETE, CGC et UCS)
Science – publié le jeudi 29 juin 2023 à 08:01

ETE
Houndekindo F et Ouarda TBMJ (2023). Comparative study of feature selection methods for wind speed 1 estimation at ungauged locations. Energy Conversion and Management, 291 (Septembre): Art. 117324. DOI : 10.1016/j.enconman.2023.117324 LA SUITE
Le congélateur faisait du bruit...
Science – publié le mercredi 28 juin 2023 à 10:04
Un préposé à l'entretien d'une université américaine a détruit accidentellement (lire: par manque de formation et/ou de jugement) des décennies de recherche universitaire américaine en éteignant un congélateur d'un laboratoire... LA SUITE
37e Symposium de l'Est du Canada sur la recherche sur la qualité de l'eau
Événements – publié le mardi 27 juin 2023 à 10:25

(English below)
Nous sommes heureux de vous annoncer le 37e Symposium de l'Est du Canada sur la recherche sur la qualité de l'eau !
Cet événement annuel, reconnu comme une référence incontournable dans le domaine, réunira les esprits les plus... LA SUITE
Un poids lourds des congrès dans le domaine de l'eau à la porte à côté
Événements – publié le lundi 26 juin 2023 à 10:42

Shaping Our Water Future, IWA World Water Congress & Exhibition
Call for Content now open / Toronto, Canada | 11-15 August 2024
https://worldwatercongress.org/
L'appel à contenu pour le Congrès IWA à Toronto, Canada, est maintenant ouvert ! Nous vous invitons... LA SUITE
Mémoires/Thèses à donner
Petites annonces – publié le jeudi 22 juin 2023 à 08:50

Ait-Ssi L (93). Modélisation stochastique du transfert des pesticides dans les sols et les eaux souterraines. Application à la vulnérabilité des puits. [Thèse présentée pour l'obtention du grade de Philosophiae Doctor (Ph.D.) en sciences de l'eau].... LA SUITE
Votre générosité ira 2 x + loin!
Au 490 – publié le mercredi 28 juin 2023 à 14:32

La Fondation de l'INRS est heureuse d’annoncer qu'une campagne de jumelage de don est en cours en soutien à une formation immersive sur l’énergie et la géothermie au Portugal organisée par un groupe... LA SUITE
Projet Trame Bleue a besoin de vous (et de votre bac à recyclage)
Au 490 – publié le mardi 27 juin 2023 à 11:39

Dans le cadre d’un projet étudiant portant sur la qualité des rivières de Québec, nous avons besoin de votre aide afin d’amasser plusieurs contenants en plastique de 2L ou plus, préférablement avec une poignée. Par exemple, un contenant... LA SUITE
Les fausses références de ChatGPT
Le saviez-vous? – publié le lundi 26 juin 2023 à 11:22

Au courant du printemps 2023, un tribunal américain a été saisi d’une cause où un plaignant poursuivait une compagnie aérienne pour une blessure accidentelle subie lors d’un vol.Dans le mémoire déposé par les avocats du... LA SUITE
Nouveaux articles scientifiques au 490 (ETE, CGC et UCS)
Science – publié le jeudi 22 juin 2023 à 09:18

ETE
Abdelkader M, Temimi M et Ouarda TBMJ (2023). Assessing the national water model’s streamflow estimates using a multi-decade retrospective dataset across the contiguous United States. Water, 15 (13): Art. 2319. DOI : 10.3390/w15132319
Miranda MA, Raymond J, Dezayes C, Wigston A et... LA SUITE
Un piano public devant l'INRS
Autour de nous – publié le jeudi 22 juin 2023 à 08:37

Le piano public qui était devant l'église St-Roch est de retour cet été mais à un nouvel emplacement : devant le jardin Jean-Paul-L’Allier donc (presque devant l'INRS!). Des travaux sur le parvis et l'église causent ce... LA SUITE